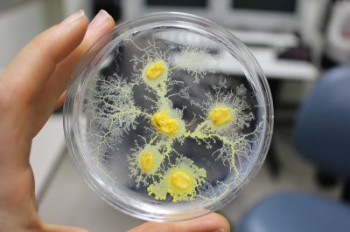

Бактериологические лаборатории США у дверей России В российском МИД озабочены размещением США медико-биологических
лабораторий вблизи российских границ, включая Грузию. Об этом говорится в
сообщении на сайте внешнеполитического ведомства.
В МИД отметили, что наиболее показателен в этом плане так называемый
Исследовательский центр общественного здравоохранения имени Лугара в
пригороде Тбилиси, представляющий собой лабораторию высокого уровня
биологической изоляции. В Москве считают, что «под ее крышей прочно
"прописалось" медицинское исследовательское подразделение сухопутных
войск США», являющееся филиалом исследовательского института имени
Уолтера Рида. В МИД отметили, что наиболее показателен в этом плане так называемый
Исследовательский центр общественного здравоохранения имени Лугара в
пригороде Тбилиси, представляющий собой лабораторию высокого уровня
биологической изоляции. В Москве считают, что «под ее крышей прочно
"прописалось" медицинское исследовательское подразделение сухопутных
войск США», являющееся филиалом исследовательского института имени
Уолтера Рида.«Американские и грузинские власти предпринимают усилия по сокрытию истинного содержания и направленности деятельности этого воинского подразделения армии США, занимающегося изучением особо опасных инфекционных болезней. Пентагон старается внедрить такие же закамуфлированные военные медико-биологические объекты и в другие государства на пространстве СНГ», — полагают в российском министерстве иностранных дел. Институт Рида расположен на севере вашингтонской агломерации в Форест-Глен (относится к штату Мэриленд) и назван в честь выдающегося военного врача-инфекциониста Уолтера Рида, открывшего механизм переноса малярии через укусы москитов. Организация, созданная в 1953 году, считается одним из ключевых военных исследовательских центров США, работающих в области эпидемиологии и защиты от биологического оружия. |
11 июня 2015
Просмотров: 4 447






